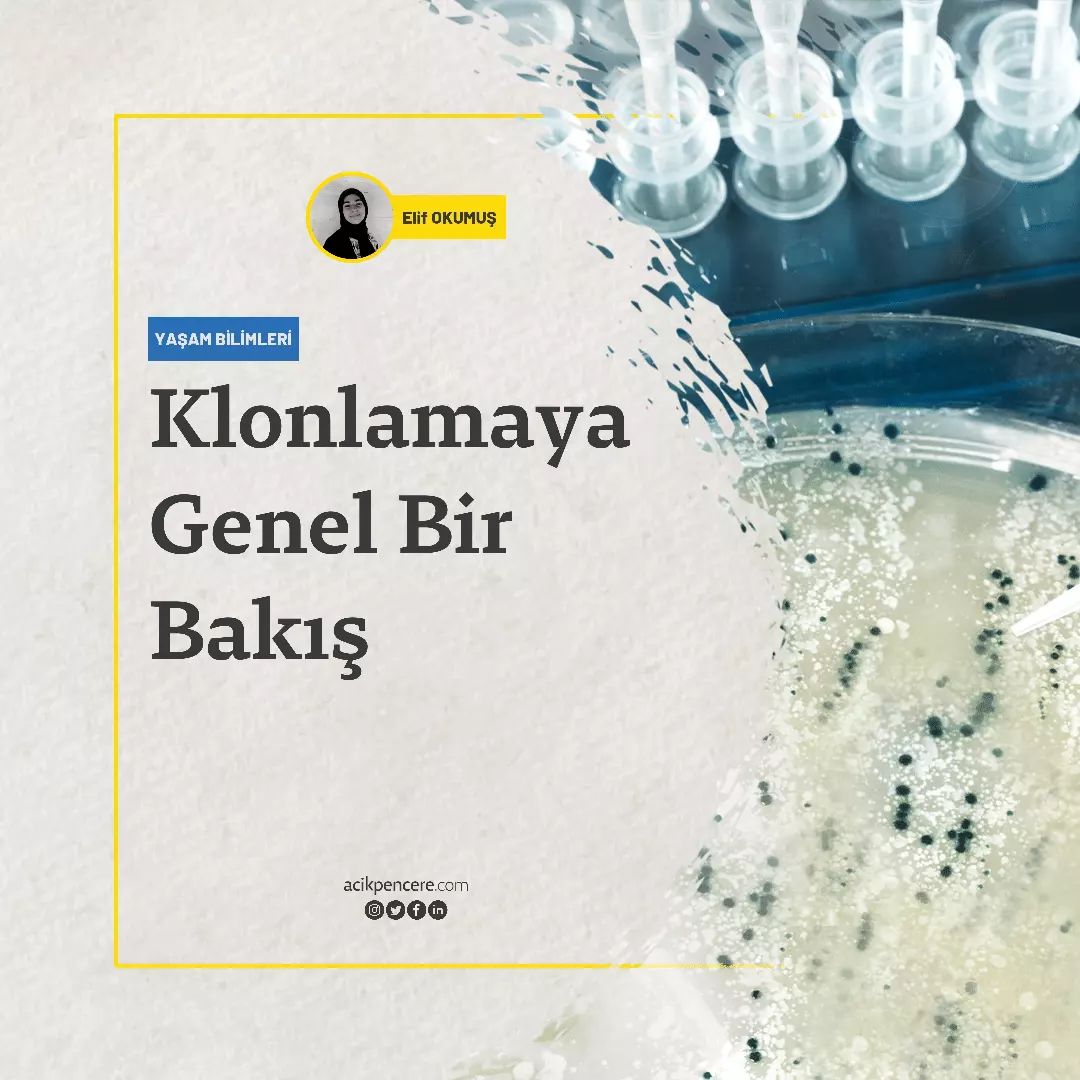

Ana Sayfa 275582292_487841839506594_5561695265478475846_n.webp 275582292_487841839506594_5561695265478475846_n.webp
Sitede yer alan fikirler yazara aittir ve Açık Pencere'nin kurumsal tercihlerini yansıtmayabilir. | The ideas contained in the site belong to the author and may not reflect the corporate preferences of AP.
© 2025 | Bu sitenin tüm hakları saklıdır.